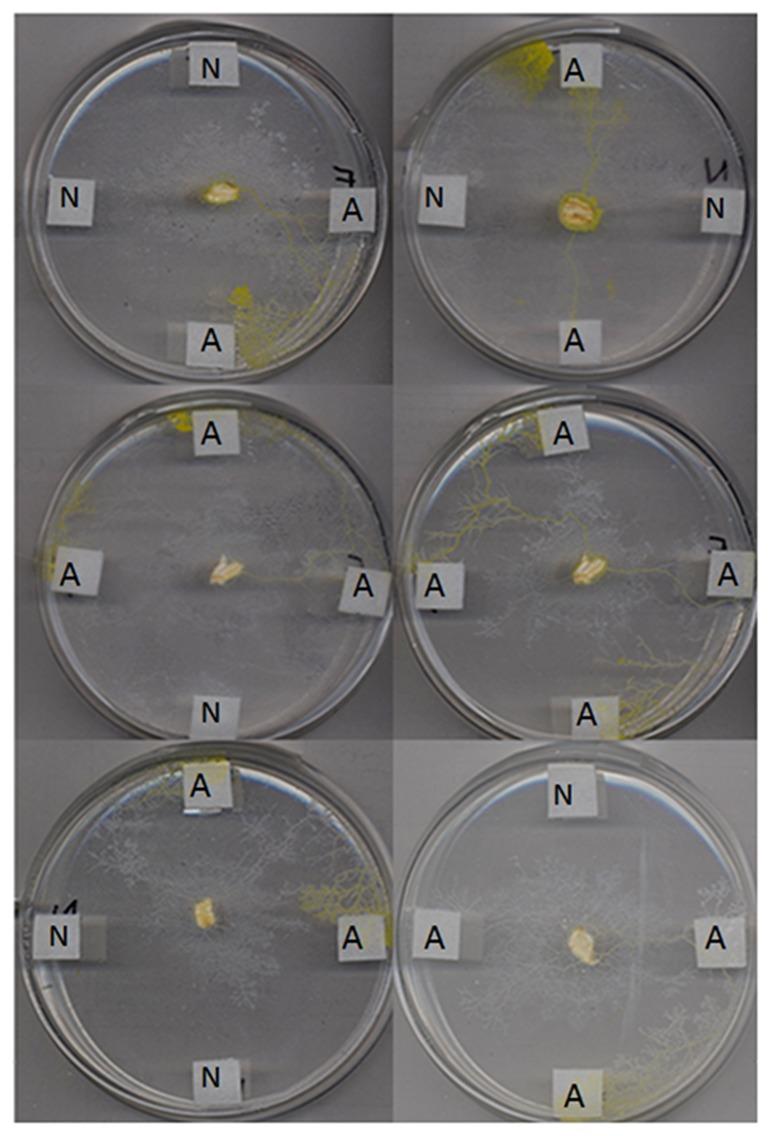

利用简单化学物质对多头绒泡菌“信号”进行路由
Routing of Physarum polycephalum "signals" using simple chemicals.
作者信息
de Lacy Costello Ben, Adamatzky Andrew I
机构信息
Institute of Biosensing Technology; University of the West of England; Bristol, UK ; Unconventional Computing Group; University of the West of England; Bristol, UK.
Unconventional Computing Group; University of the West of England; Bristol, UK.
出版信息
Commun Integr Biol. 2014 Apr 4;7:e28543. doi: 10.4161/cib.28543. eCollection 2014.
In previous work the chemotaxis toward simple organic chemicals was assessed. We utilize the knowledge gained from these chemotactic assays to route Physarum polycephalum "signals" at a series of junctions. By applying chemical inputs at a simple T-junction we were able to reproducibly control the path taken by the plasmodium of P. Polycephalum. Where the chemoattractant farnesene was used at one input a routed signal could be reproducibly generated i.e., P. Polycephalum moves toward the source of chemoattractant. Where the chemoattractant was applied at both inputs the signal was reproducibly split i.e., at the junction the plasmodium splits and moves toward both sources of chemoattractant. If a chemorepellent was used then the signal was reproducibly suppressed i.e., P. Polycephalum did not reach either output and was confined to the input channel. This was regardless of whether a chemoattractant was used in combination with the chemorepellent showing a hierarchy of inhibition over attraction. If no chemical input was used in the simple circuit then a random signal was generated, whereby P. Polycephalum would move toward one output at the junction, but the direction was randomly selected.
在之前的工作中,对朝向简单有机化学物质的趋化性进行了评估。我们利用从这些趋化性测定中获得的知识,在一系列交叉点处引导多头绒泡菌的“信号”。通过在一个简单的T型交叉点施加化学输入,我们能够可重复地控制多头绒泡菌的原质团所采取的路径。在一个输入处使用化学引诱剂法尼烯时,可以可重复地产生一个被引导的信号,即多头绒泡菌朝着化学引诱剂的来源移动。在两个输入处都施加化学引诱剂时,信号会可重复地分开,即在交叉点处原质团分开并朝着两个化学引诱剂来源移动。如果使用化学驱避剂,那么信号会可重复地被抑制,即多头绒泡菌不会到达任何一个输出端,而是局限于输入通道。这与化学引诱剂是否与化学驱避剂结合使用无关,显示出抑制相对于吸引的等级关系。如果在简单电路中不使用化学输入,那么会产生一个随机信号,由此多头绒泡菌会在交叉点处朝着一个输出端移动,但方向是随机选择的。